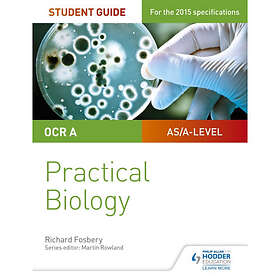

Practical guide






Neal Lozano, John Sandford: Unbound A Practical Guide to Deliverance
English, Paper Books
from
£10.90







from
£61.12





















Practical guide to the runes their uses in divination and magick (pocket, eng)
English, Paper Books
from
£7.87





from
£44.99